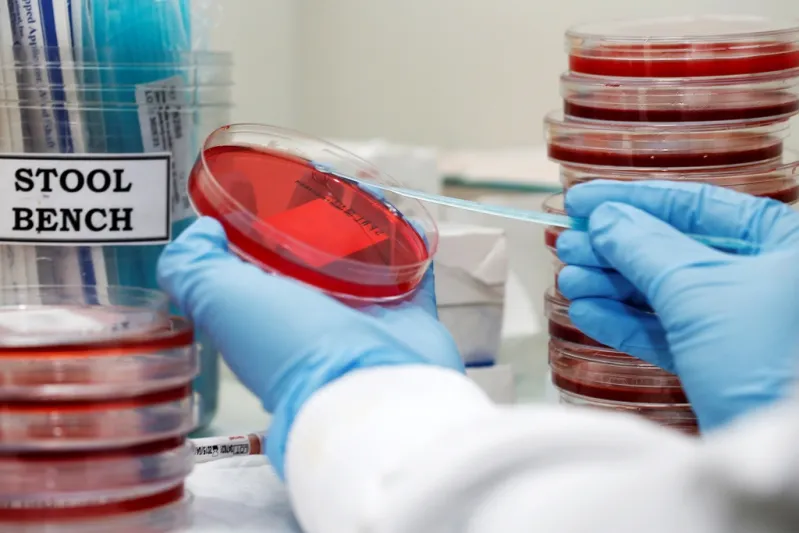
الباحث السعودي حسام الزواوي:  محارب "البكتيريا الخارقة"

الباحث السعودي حسام الزواوي: محارب "البكتيريا الخارقة"

الرجل-دبي:
والده مربّي نحل، أهداه قريب لهم "مجهراً" لرؤية حبوب اللقاح، لكنه لم يستخدمه، فأخذه الطفل ذو السنوات السبع ليلعب به مع أخيه، ومن خلاله اكتشف عالماً لم يتخيّل وجوده، وهو العالم الذي لا يمكن رؤيته بالعين المجردة، حيث كان يرىالنمل تحته كبيراً للغاية. ومن هنا بدأت رحلته مع الاستكشاف والمختبرات. إنه الشاب السعودي حسام الزواوي، الذي تحدث إلى "الرجل" عن قصة نجاحه.
انا حسام الزواوي مبتعث سعودي من وزارة الشؤون الصحية في الحرس الوطني- جامعة الملك سعود بن عبد العزيز للعلوم الصحية. بدأ اهتمامي العلمي مذ كان عمري سبع سنوات، وكان لدى والدي هواية تربية النحل. وذات مرة زارنا قريب لنا وأهدى والدي "ميكروسكوب" (مجهر)، وكان الهدف منه ان يرى والدي حبوب اللقاح تحت المجهر ويكشف عن العسل،لكن والدي لم يستعمله البتة، فأخذت انا وأخي نلعب بهذا المجهر، ومن خلاله اكتشفت عالماً لم اتخيّل وجوده، وهو العالم الذي لا يمكن رؤيته بالعين المجردة، وقد كنت في البداية ارى النمل تحت هذا المجهر كبيراً للغاية، ثم بدأ الموضوع يصغر أكثر فأكثر حتى بدات اهتم بالبكتيريا.
من هنا كانت البداية..
هدية والدي هي التي فتحت الآفاق امامي، وبعدها وفي نهاية المدرسة دخلت كلية العلوم وتخصّصت في علم الاحياء الدقيقة، وخلال دراستي تعرفت الميكروبات المسببة لأمراض عدة معدية، ومن خلالها عرفت البكتيريا المقاومة للمضادات الحيوية، وكانت هذه المشكلة الموجودة منذ عشر سنوات الى يومنا هذا، وفي الوقت نفسه درست طريقة تحليل الميكروبات، وهي طريقة معقدة جداً وطويلة وتأخذ نحوأربعة ايام، وكان السؤال الذي يستوقفني دائماً: لماذا تعدّ هذه البيكتيريا مقاومة للمضادات الحيوية؟ وكيف نستطيع تطوير التحاليل الطبية ونجعلها لفترات اقصر؟ وبعد الجامعة عملت أخصائيّ مختبر، ومن خلال هذه الممارسة اكتشفت وجود مشكلة حقيقية للبكتيريا المقاومة للمضادات الحيوية، فقد كنت أقرأ تقارير المرضى وأرى ان مريضاً دخل لعلاج ما او عملية، ولكن بعد ساعات او ايام قليلة كان يُصاب بعدوى، وكان سبب هذه العدوى البكتيريا المقاومة للمضادات الحيوية من المستشفى، والمعروفة باسم "العدوى المكتسبة من المستشفيات"، وكان هذا بالنسبة لي كبيراً جداً، لأني كنت أقرأ عنها في الكتب، ولكنني الان اعيش التجربة عندما ارى المرضى الذين يعانون. ثم خرجت من المختبر وبدأت اعمل ممارس مكافحة العدوى، وهذه الوظيفة تتطلب منك ان تقرأ تقارير المرضى، وفي بعض الاحيان ان تراهم، وفي هذه المرحلة شهدت حالات عدة في المستشفيات من العدوى المكتسبة، حيث كانت منتشرة بشكل كبير في المستشفيات، وقد كنت أقرأ عنها كثيراً في التقارير والأوراق العلمية والأبحاث. بعد ذلك وصلت إلى مرحلة ان هذا فعلا مجال يجب ان ابحث فيه، فانتقلت الى جامعة "طيبة" في المدينة المنورة، فقمت بعمل بحث لاأول مرة، وهو دراسة مدى انتشار الميكروبات في جوّالات الاطباء والممرضات، طبعاً اكتشفنا انواعاً عدة من ضمنها "إم آر إس آي"، وهذا نوع مشهور جداً من الميكروبات الشديدة المقاومة، ولكن هذا البحث وضح لي انني احتاج الى خبرة اكثر في مجال الابحاث لأقوم بأبحاث معقدة، وبسبب هذا الموضوع قررت الانتقال الى جامعة اخرى عرضت عليّ البعثة لإكمال الماجستير والدكتوراه لدراسة الاحياء الدقيقة الاكلينيكية والامراض المعدية، وبعدها انتقلت الى استراليا وبدأت ابحاثي التي ركزت فيها على العدوى المكتسبة في المستشفيات، وخاصة المقاومة للمضادات الحيوية.
بدأنا ابحاثنا بإنشاء اول شبكة بحثية بين مستشفيات عدّة في دول مجلس التعاونالخليجي، وهي اول شبكة خليجية تهتمّ بمدى انتشار البكتيريا المقاومة للمضادات الحيوية في دول المنطقة، وطبعاً اهمية هذا البحث ليست اهمية محلية فقط،ولكن عالمية، حيث نستطيع بناء صورة عامة عالمية عن الميكروبات المقاومة للمضادات الحيوية.
نحن الآن نأخذ نحو اربعة ايام لاكتشاف اذا كانت البكتيريا مقاومة للمضادات الحيوية أم لا، وإذا نجحنا وقلصنا هذه الفترة الى ساعات فسنقطع شوطاً كبيراً جدا في التعرف على البكتيريا، وهذا سيساعد في علاجها والتحكم فيها بشكل أسرع وأكبر، وخلال دراستنا اكتشفنا كذلك ان هناك اسباباً متعددة ادت الى انتشارها في الخليج، من ضمنها الاستخدام غير السليم للمضادات الحيوية، ومن هنا بدأت حملة شعبية طلابية، كانت في البداية تهدف الى زيادة الوعي في الخليج بأهمية الاستخدام السليم للمضادات الحيوية، بدأناها من خلال وسائط التوصل الاجتماعي، وهدفنا التوسّع للاعلام المرئي، واليوم وصلنا الى مجلة "الرجل" وغيرها من وسائل الإعلام، لتوعية الناس بالخطر الذي يمكن ان تسببه البكتيريا المقاومة للمضادات الحيوية، وأهمية الاستخدام السليم لها، ونخطط الآن لعمل فعاليات رياضية.
تكريم التايمز
نشرت مجلة التايم TIME الأمريكية الشهيرة ضمن قادة الجيل القادم صفحات مطولة عن حسام زواوي من مركز كوينزلاند للأبحاث السريرية ، بجامعة كوينزلاند نظير مشاريعه البحثية الابتكارية في حماية صحة الإنسان من خطر البكتيريا المقاومة للمضادات الحيوية (Superbugs).
و فاز زواوي بجائزة جامعة جريفيث للتفوق العلمي عام 2010 Griffith University Award for Academic Excellence ، وحصل على جائزة رولاكس للمشاريع الطموحة Rolex Awards for Enterprise لتكريم قادة المستقبل في مجالات العلوم والصحة والتكنولوجيا والإستكشاف والبيئة والتراث، الجائزة تعطى كل عامين لخمسة أشخاص مبادرين بغرض الاحتفاء بهم ودعم جهودهم في مواجهة التحديات العالمية الكبرى.
* اذا طلبنا منك ان تلخّص لنا إنجازك بجملة،فماذا تقول؟
انا لا اقول انه انجاز ولكن هو اعتراف بأهمية عملنا، حيث حصلنا على جائزة "رولكس" للمشاريع الطموحة التي تدعم المشاريع في المستقبل إنشاء الله، وهي جائزة عريقة قدمتها إلى 130 باحثاً من مختلف انحاء العالم.
* هل سبق أن قام احد بتقديم مثل بحثك؟
هو البحث الوحيد الى الان في العالم، فهو لم يركز على شق واحد، بل على ثلاثة، الاول هو الشبكة البحثية لدراسة مدى انتشار الميكروبات في المنطقة.والثاني تطوير تحاليل طبية جديدة ابتكارية. والثالث هو التوعية وهذا مايجعل بحثنا فريداً.
* من يدعمك؟
في البداية كانت الحكومة السعودية تدعمني، ثم في استراليا اخذت الدعم من مركز الملك عبدالله العالمي للابحاث التابع لوزارة الحرس الوطني، وساعدني هدا الدعم على انشاء الشبكة البحثية.
* ما الوقت الذي تقضيه لخدمة هذا البحث يومياً؟
انا بدون مبالغة اعمل يومياً من 12 الى 16 ساعة.
* ما طبيعة العمل؟
اولاً لتكوين الشبكة البحثية يجب عليك التعامل مع اطباء وباحثين في مختلف دول العالم، وكل حسب وقته، حيث يجب ارسال االرسائل الالكترونية وإجراء الاتصالات، كما أن عليّ السفر كثيراً. وهناك ايضا الشق المختبري الذي يحتاج إلى ان اكون داخل المختبر اعمل مع البكتيريا مباشرة، وأقوم بالتحاليل الطبية وأحاول ان احللها وأتعرف السبب الذي يجعلها مقاومة للمضادات الحيوية، والسبب الاخر هو كيف أعرفها بشكل سريع، والشق الثالث هو وسائل التواصل الاجتماعي، حيث احاول عمل الفيديو والتويت ونحاول نشر التوعية.
* ما هي علاقتك بالبكتيريا؟؟
هي خطر يهدد صحة الانسان، حيث قاومها البشر بعد اكتشاف أليكساندر فليمنغ في عام 1928، وقد قلّ هذا الخطر بشكل كبير، ولكن بعد ظهور البكتيريا المقاومة للمضادات الحيوية التي تأخذنا للفترة التي تسبق اكتشافها، ستكون هذه البكتيريا والامراض المعدية خطراً يهدد الانسان في المستقبل.
* ما هو هدفكم الاساسي حيال هذه البكتيريا؟
هدفنا الاساسي هو التعرف السريع إليها، وزيادة الوعي بأهمية الاستخدام السليم للبكتيريا المقاومة للمضادات الموجودة الان، لأنه ليست جميع البكتيريا الان مقاومة للمضادات الحيوية، ولكن اذا استهلكنا المضادات الحيوية أوأسأنا استعمالها،فستكون ضارة.
* في هذا المجال ما حلمك وما هدفك الأكبر؟
في البداية يجب الاعتراف بشيء واحد، إنه مهما ركزنا عملنا فمن الصعب مقاومة التهديد البكتيري للانسان، فالانسان كان مهدداً بكتيرياً وسيبقى، ولكن حلمي ان نحافظ فعلاً على المضادات الحيوية الموجودة حالياً ونستخدمها في حاجتنا بالطريقة المحددة لها، وهذا الحلم يمكن تحقيقه عن طريق التوعية او الحل السريع، لأن المشكلة ان الاطباء عند وصفهم للمضادات الحيوية في بعض الاحيان، يستخدمونها بناء على التخمين.
* انت تقول انك تعمل لمدة 16 ساعة، ما الامل الذي يدفعك للعمل كل هذا الوقت؟
الامل هو ان نساعد البشرية لتقليص الامراض المعدية بشكل عام، وخاصة العدوى التي تسببها البكتيريا المقاومة للمضادات الحيوية.
* ما الدعم الذي تتلقاه من الأهل؟
كبير جداً، انا اعيش بعيداً عن اهلي منذ سبع سنوات، فحينما ازورهم استطيع المكوث معهم اسبوعاً فقط، انا متزوج وعندي طفلة، فمن دون دعمهم وصبرهم ماكنت وصلت الى هنا.
* ما فلسفة النجاح بالنسبة إلى شاب مثلك؟
النجاح بالنسبة لي ليس شخصياً، فأنا جزء صغير من كيان كبير يتكون من باحثين متطوعين وأطباء، ولكن النجاح بالنسبة لنا ان نكون فعلاً اثرنا في حماية الانسان من العدوى التي تسببها البكتيريا المقاومة للمضادات الحيوية.
* بماذا يختلف الشاب السعودي عن الأميركي الذي يبدع وينجز ويصل الى مراحل متقدمة جدا لخدمة البشرية؟
لاشيء؛ الفرق الوحيد هو انه يتوجب علينا زيادة التواصل مع العالم خارج السعودية، لنثبت ان الشاب السعودي مثله مثل غيره، عنده القدرة على الابداع، كما أنه يستطيع وضع بصمة عالمية في كثير من المجالات.
* ما الرسالة التي توجهها للشاب السعودي؟
قدرات الشاب السعودي كبيرة، وخاصة مع الدعم الموجود، حيث ان التعليم مجاني وهذه نعمة كبيرة، ومراكز الابحاث مفتوحة. يجب على الشخص الاستمرار في المبادرة، فهي بداية الطريق للنجاح.
* هل انت متفائل بالمستقبل على المستوى البحثي؟
خلال السنتين الماضيتين لم نحصل على دعم بحثي بأكثر من مئتين او ثلاثمئة الف دولار. العالم العربي، وخاصة الخليج، لديه القدرة على الصرف للأبحاث الطبية والعلمية، فقد خطونا خطوات كبيرة في هذا المجال، فهي مهمة جداً، فإذا كان العالم الغربي الآن غير قادر على الاستمرار بسبب قلة الدعم، فهذا الآن وقتنا، ليكون عندنا مجال للابداع، بحكم وجود مراكز الابحاث المصروف عليها مليارات، فضلاًعن وجود المنح البحثية، ووجود العقول العربية.
* هل تحب توجيه رسالة؟
الابحاث الطبية مكلفة جداً، فمهما كان دعم الحكومة كبيراً جداً، يبقى الباحث في المجال الطبي بحاجة اكبر الى الدعم المادي، وليس الدعم المادي فقط،ولكن اللوجيستي ايضاً،فمن المهم ان يسهم رجال الاعمال في المنطقة في دعم الابحاث العلمية عن طريق الكراسي البحثية، او التبرعات للابحاث، فالتبرعات ضعيفة في هذا المجال نوعاً ما.



















